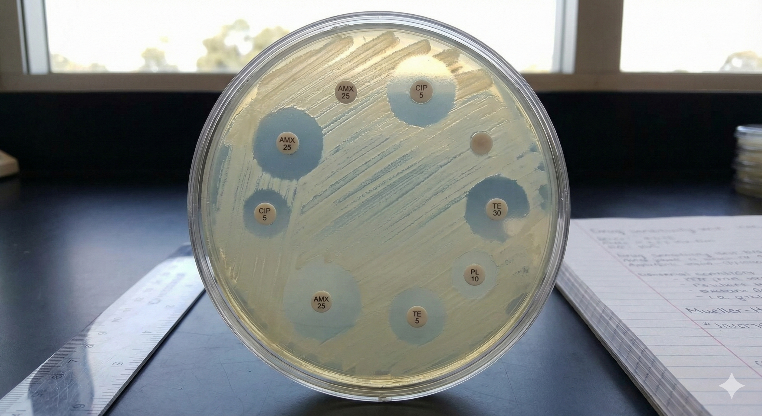
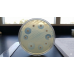
ISCAID 犬膿皮病臨床診療與抗微生物使用指南深度解析

這是一份基於國際伴侶動物傳染病學會(ISCAID)最新發布的《犬膿皮病抗微生物使用指南》所整理的專業臨床知識文。本文旨在為臨床獸醫師提供關於犬葡萄球菌性膿皮病(含MRSP)的診斷、分類及抗微生物管理(Antimicrobial Stewardship)的深度解析。
核心節錄: 犬膿皮病(Canine Pyoderma)是小動物臨床中最常見的皮膚病之一,同時也是抗生素處方的主要來源。隨著多重抗藥性(MDR)細菌— 特別是耐甲氧西林偽中間型葡萄球菌(MRSP)的盛行,傳統經驗性用藥已面臨挑戰。ISCAID 透過系統性回顧截至2023年底的實證醫學文獻,發布了針對犬膿皮病的全面指南。本指南的核心範式轉移在於:從「全身性抗生素優先」轉向「局部治療優先」,並強調精確診斷與抗微生物管理的重要性。
一、 精確診斷:三步策略 (The Three-Step Diagnostic Approach)
指南強調,為了減少不當抗生素使用並避免復發,必須嚴格執行「三步診斷法」。
1. 皮膚檢查與病變評估
2. 細胞學檢查(Cytology):不可或缺的基石
細胞學是區分「定植(Colonization)」與「感染(Infection)」的黃金標準,也是啟動任何抗微生物治療的前提。
臨床價值:
確認細菌存在及其形態(球菌 vs 桿菌)。
評估炎症反應(是否觀察到中性球吞噬細菌)。
排除非細菌性病因(如落葉性天皰瘡、馬拉色菌皮炎)。
意義:若細胞學未見細菌,即便臨床症狀相似,亦不應使用抗生素。
3. 尋找潛在原發病因
「膿皮病永遠是繼發的」。 若不解決原發病因,復發是必然的。
最低診斷數據集(Minimum Database):
毛髮刷拭(Coat brushing):檢查跳蚤、Cheyletiella spp.。
拔毛檢查(Trichography):檢查蠕形蟎(Demodex)、黴菌孢子。
皮膚刮片(Skin scrapings):深層與淺層刮片,排除疥癬蟲與蠕形蟎。
進階檢查:內分泌檢測、過敏原排除試驗、組織病理學。
二、 細菌培養與藥敏試驗 (BC/AST) 的適應症
並非所有病例均需進行細菌培養。指南明確界定了BC/AST的應用時機,以優化資源並精準用藥。
絕對適應症:
深層膿皮病(Deep Pyoderma):必須進行。
抗藥性高風險群:近期頻繁使用抗生素、曾分離出MRSP/MRSA、或該地區MRSP盛行率極高。
全身性治療無效:經驗性用藥失敗時。
採樣:
淺層感染:挑選完整的膿皰。
深層感染:表面拭子(Swab)易造成誤導。必須採集**活檢組織(Biopsy)**或從無菌消毒後的深層病灶抽取滲出液。
三、 臨床分類與治療策略
指南根據感染深度將膿皮病分為三類,並制定了相應的治療階梯。
1. 表面膿皮病 (Surface Pyoderma)
定義:細菌僅在角質層表面過度生長,如創傷性濕疹(熱點)、間擦疹(皺褶炎)。
治療準則:禁止使用全身性抗生素。
首選方案:局部抗微生物療法。
優先使用消毒劑(Antiseptics),如 2%-4% 洗必泰(Chlorhexidine)。
輔助療法:局部皮質類固醇(消炎)與清潔乾燥。
2. 淺層膿皮病 (Superficial Pyoderma)
定義:感染累及毛囊(細菌性毛囊炎),表現為紅斑丘疹、膿皰、表皮環。
治療準則:局部治療是首選,全身性抗生素為二線選擇。
局部療法:
對於廣泛病變,建議每週使用 2-3 次含 2%-4% 洗必泰的藥浴,接觸時間需達 10-15 分鐘。
對於局部病灶,可每日使用慕斯、噴劑或濕巾。
全身性治療:僅保留給局部治療失敗或飼主無法配合的案例。
療程監控:初始治療 2 週。必須在療程結束前複診。若症狀改善但未全癒,需延長治療至臨床症狀與細胞學完全緩解。
3. 深層膿皮病 (Deep Pyoderma)
定義:感染突破毛囊進入真皮與皮下組織(癤病、蜂窩織炎),伴隨出血性結痂、引流竇道、劇痛。
治療準則:必須使用全身性抗生素,且必須基於 BC/AST 結果選擇藥物。
輔助療法:一旦疼痛緩解,應立即加入局部消毒劑治療,以縮短病程。
療程:通常需 3 週以上。建議在病變完全緩解後,再持續治療 2 週。
四、 抗微生物藥物分級管理 (Antimicrobial Stewardship)
當必須使用全身性抗生素時,臨床獸醫師應嚴格遵循藥物分級制度。
第一級:首選藥物 (First Line)
適用情況:經驗性治療的首選,預期對大多數敏感葡萄球菌有效,副作用風險低。
藥物:
Cephalexin / Cefadroxil (第一代頭孢菌素)
Amoxicillin-Clavulanate
Clindamycin / Lincomycin
第二級:次選藥物 (Second Line)
適用情況:僅在 BC/AST 證實第一級藥物無效,且該藥物敏感時使用。
風險:可能增加抗藥性選擇壓力或副作用。
藥物:
Cefovecin / Cefpodoxime (第三代頭孢菌素)
Fluoroquinolones (如 Enrofloxacin, Marbofloxacin, Pradofloxacin)
Doxycycline / Minocycline
Potentiated Sulfonamides
第三級:保留藥物 (Must be Reserved)
適用情況:最後防線。僅限於治療多重耐藥菌(如 MRSP),且 BC/AST 顯示無其他選擇時。使用需經過倫理與風險評估。
藥物:
Chloramphenicol (需注意骨髓抑制副作用)
Rifampin (肝毒性風險,需監測)
Amikacin (腎毒性風險)
禁用藥物
Vancomycin, Linezolid:這些藥物對人類醫學至關重要(治療 MRSA/VRE),嚴禁用於動物臨床。
五、 特殊考量:MRSP 與 復發管理
耐甲氧西林葡萄球菌 (MRSP)
MRSP 的臨床表現與敏感菌株無異,診斷全賴細菌培養。
治療核心:局部消毒劑(洗必泰)對 MRSP 依然有效,應作為表面與淺層 MRSP 感染的主力治療。
公衛:雖人畜共通風險低於 MRSA,但仍需告知飼主並實施嚴格的手部衛生與環境消毒。
復發性膿皮病 (Recurrent Pyoderma)
若犬隻需反覆接受抗生素治療,即代表診斷流程不完整。
處置策略:
停止依賴抗生素抑制症狀。
重新啟動原發病因調查(特別是異位性皮膚炎、內分泌疾病)。
主動維持療法:對於無法根除原發病因的病例,建議長期、規律使用局部消毒劑(每週藥浴或每日局部護理)來預防復發,而非長期低劑量給予抗生素。
六、 結論
ISCAID 指南傳遞了明確的訊息:皮膚科是實踐抗微生物管理的最佳領域。 透過嚴謹的細胞學檢查、優先採用局部消毒劑療法,以及嚴格依據 BC/AST 結果分級使用抗生素,臨床獸醫師不僅能有效治療膿皮病,更能為減緩全球抗藥性危機做出關鍵貢獻。未來的治療趨勢將更側重於恢復皮膚微生態平衡,而非單純的殺滅細菌。

參考資料:
Antimicrobial use guidelines for canine pyoderma by the International Society for Companion Animal Infectious Diseases (ISCAID). Loeffler A, et al. Vet Dermatol. 2025. PMID: 40338805
標籤: 11/26 ISCAID 犬膿皮病臨床診療與抗微生物使用指南深度解析, 11/26 ISCAID 犬膿皮病臨床診療與抗微生物使用指南深度解析, 最新消息